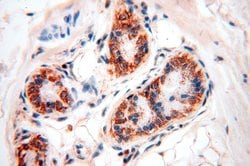
MRPL46 Rabbit anti-Human, Mouse, Rat, Polyclonal, Proteintech:Antibodies:Primary
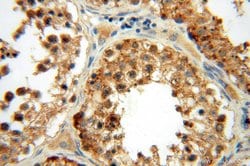
MRPL46 Rabbit anti-Human, Mouse, Rat, Polyclonal, Proteintech:Antibodies:Primary
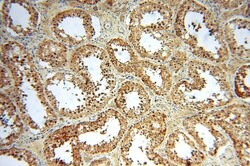
MRPL46 Rabbit anti-Human, Mouse, Rat, Polyclonal, Proteintech:Antibodies:Primary

missing translation for 'onlineSavingsMsg'
Learn More
Learn More
MRPL46 Rabbit anti-Human, Mouse, Rat, Polyclonal, Proteintech
Rabbit Polyclonal Antibody
£135.00 - £349.00
Specifications
| Antigen | MRPL46 |
|---|---|
| Concentration | 0.27 mg/mL |
| Applications | Immunohistochemistry (Paraffin), Western Blot, Immunofluorescence, Immunocytochemistry |
| Classification | Polyclonal |
| Conjugate | Unconjugated |
| Product Code | Brand | Quantity | Price | Quantity & Availability | |||||
|---|---|---|---|---|---|---|---|---|---|
| Product Code | Brand | Quantity | Price | Quantity & Availability | |||||
|
16876274
|
Proteintech
16611-1-AP-20UL |
20 μL |
£135.00
20µL |
Please sign in to purchase this item. Need a web account? Register with us today! | |||||
|
16866274
|
Proteintech
16611-1-AP-150UL |
150 μL |
£349.00
150µL |
Please sign in to purchase this item. Need a web account? Register with us today! | |||||
Description
Mammalian mitochondrial ribosomal proteins are encoded by nuclear genes and help in protein synthesis within the mitochondrion. Mitochondrial ribosomes (mitoribosomes) consist of a small 28S subunit and a large 39S subunit. They have an estimated 75% protein to rRNA composition compared to prokaryotic ribosomes, where this ratio is reversed. Another difference between mammalian mitoribosomes and prokaryotic ribosomes is that the latter contain a 5S rRNA. Among different species, the proteins comprising the mitoribosome differ greatly in sequence, and sometimes in biochemical properties, which prevents easy recognition by sequence homology. This gene encodes a 39S subunit protein.Specifications
| MRPL46 | |
| Immunohistochemistry (Paraffin), Western Blot, Immunofluorescence, Immunocytochemistry | |
| Unconjugated | |
| Rabbit | |
| Rat, Mouse, Human | |
| Q5RK00, Q9EQI8, Q9H2W6 | |
| 26589, 293054, 67308 | |
| MRPL46 Fusion Protein Ag9837 | |
| Primary | |
| -20°C | |
| MRPL46 |
| 0.27 mg/mL | |
| Polyclonal | |
| Liquid | |
| RUO | |
| PBS with 50% glycerol and 0.02% sodium azide; pH 7.3 | |
| C15orf4, L46mt, LIECG2, MRP L46, MRPL46, P2ECSL | |
| Mrpl46 | |
| IgG | |
| Antigen Affinity Chromatography | |
| Antibody |
Spot an opportunity for improvement?Share a Content Correction
Product Content Correction
Your input is important to us. Please complete this form to provide feedback related to the content on this product.
Product Title